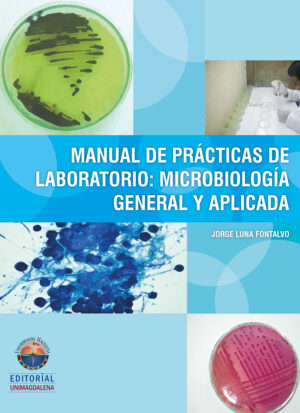
MANUAL DE PRÁCTICAS DE LABORATORIO: MICROBIOLOGÍA GENERAL Y APLICADA

Tienda
Mostrando 23851–23900 de 41962 resultadosOrdenado por los últimos
-

LA AMBIVALENCIA DE EVA
$15.00 Añadir al carrito -

MEMORIAS Y NARRATIVAS
$15.00 Añadir al carrito -

VALORACIÓN Y CUIDADO DE ENFERMERÍA A NIÑOS Y NIÑAS EN LA SEGUNDA INFANCIA Y LA ADOLESC
$14.00 Añadir al carrito -

CUENTOS FELINOS 8
$14.00 Añadir al carrito -

EL APRENDIZAJE INICIAL DE LA LENGUA ESCRITA
$14.00 Añadir al carrito -

RECUPERACIÓN DE TIERRAS EN EL PUEBLO ZENÚ
$14.00 Añadir al carrito -

RAÚL GÓMEZ JATTIN
$14.00 Añadir al carrito -

LA CIUDAD INTELIGENTE Y LA GESTIÓN DE LAS TIC
$14.00 Añadir al carrito -

RECLUSAS DE LA CÁRCEL RODRIGO DE BASTIDAS DE SANTA MARTA
$14.00 Añadir al carrito -

EL GUION CINEMATOGRÁFICO COMO PIEZA AUDIOVISUAL AUTÓNOMA
$14.00 Añadir al carrito -

APORTES DE LA ANTROPOLOGÍA FORENSE EN LA INVESTIGACIÓN DE CRÍMENES DE LESA HUMANIDAD EN
$14.00 Añadir al carrito -

HOW TO BECOME A SUCCESSFUL ENGLISH SPEAKING TOURIST GUIDE IN THE CITY OF SANTA MARTA, COLO
$14.00 Añadir al carrito -

UN ACERCAMIENTO A LA METACOGNICIÓN Y LA COMPRENSIÓN LECTORA EN ESTUDIANTES UNIVERSITARIO
$14.00 Añadir al carrito -

LA TRASTIENDA DE MELQUÍADES
$13.00 Añadir al carrito -

CUENTOS FELINOS 7
$13.00 Añadir al carrito -

CUENTOS FELINOS 6
$13.00 Añadir al carrito -

HUELLAS DE SAN AGUSTÍN EN KANT
$13.00 Añadir al carrito -

CUENTOS FELINOS 5
$13.00 Añadir al carrito -

MANUAL DE CIENCIA CIUDADANA
$13.00 Añadir al carrito -

CONTRATOS INTELIGENTES
$13.00 Añadir al carrito -

TIEMPOS DE PANDEMIA
$13.00 Añadir al carrito -

COMPRENSIONES EMERGENTES SOBRE CALIDAD EDUCATIVA DESDE LA PERSPECTIVA DEL DESARROLLO IDENT
$13.00 Añadir al carrito -

CUENTOS FELINOS 2
$13.00 Añadir al carrito -

HISTORIAS PERVERSAS PARA CONTARTE
$13.00 Añadir al carrito -
MANUAL DE PRÁCTICAS DE LABORATORIO: MICROBIOLOGÍA GENERAL Y APLICADA
$13.00 Añadir al carrito -

LA PLANEACIÓN DE CLASES
$12.00 Añadir al carrito -

ANTROPOLOGÍA FORENSE Y VIOLACIONES AL DERECHO INTERNACIONAL HUMANITARIO
$12.00 Añadir al carrito -

EMOCIONES, INTELIGENCIAS MÚLTIPLES Y RENDIMIENTO ACADÉMICO EN UNIVERSITARIOS
$12.00 Añadir al carrito -

TRES PARA UNA MESA (CUENTOS)
$12.00 Añadir al carrito -

NORMAS PARA LA PRESENTACIÓN DE INFORMES FINALES DE INVESTIGACIÓN Y ARTÍCULOS CIENTÍFIC
$12.00 Añadir al carrito -

LA FACTURA CAMBIARIA
$12.00 Añadir al carrito -

PREPARACIÓN PARA LA MATERNIDAD
$12.00 Añadir al carrito -

CAZADORES DE NUBES
$12.00 Añadir al carrito -

ACCIONES EDUCATIVAS EN LA ESCUELA PARA LA PRIMERA INFANCIA
$12.00 Añadir al carrito -

SANTA MARTA POÉTICA: DECIR DE OTRO MODO LO POLÍTICO
$12.00 Añadir al carrito -

CUENTOS DEL CAMPUS
$12.00 Añadir al carrito -

SENTIDOS Y SIGNIFICADOS DE JUSTICIA, PAZ Y GOBERNABILIDAD
$12.00 Añadir al carrito -

TELECOMUNICACIÓN ANALÓGICA
$12.00 Añadir al carrito -

INTERPELACIONES INTERCULTURALES EN EL CURRÍCULO DE LAS ESCUELAS DEL RETORNO
$12.00 Añadir al carrito -

EL SUICIDIO
$12.00 Añadir al carrito -

UNA VOZ OCULTA: TRAZOS, LETRAS Y POEMAS
$12.00 Añadir al carrito -

HISTORIAS DE LA DEPRESIÓN MOMPOSINA
$11.00 Añadir al carrito -

CUENTOS FELINOS 3
$11.00 Añadir al carrito -

EL BANCO DE LAS ÁNIMAS: VALORACIÓN DE SU BIODIVERSIDAD
$11.00 Añadir al carrito -

LAS PALOMAS DE LA GUERRA Y OTROS RELATOS
$11.00 Añadir al carrito -

ONDAS DE CHOQUE EXTRACORPÓREAS RADIALES
$11.00 Añadir al carrito -

ESPECIES COMUNES DEL BOSQUE SECO EN EL CÁMPUS DE LA UNIVERSIDAD DEL MAGDALENA
$10.00 Añadir al carrito -

MANUAL PARA EL CULTIVO Y PROCESAMIENTO DE PEPINO DE MAR
$10.00 Añadir al carrito -

GUÍAS DE LABORATORIO DE RESISTENCIA DE MATERIALES
$10.00 Añadir al carrito -

DESCRIPCIÓN MORFOLÓGICA DE 13 INTRODUCCIONES DE MAIZ PROCEDENTE DEL DEPARTAMENTO DEL MAG
$9.00 Añadir al carrito
